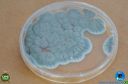
Filename=DSC_7288.jpg
Filesize=157KiB
Dimensions=960x636
Date added=Apr 11, 2023 DSC_7288.jpg

Last additions - 09/04/2023 - Expo Londrina 2023 - Smart Farm
|

46 viewsApr 11, 2023
|
|

49 viewsApr 11, 2023
|
|

40 viewsApr 11, 2023
|
|

46 viewsApr 11, 2023
|
|

49 viewsApr 11, 2023
|
|

46 viewsApr 11, 2023
|
|

44 viewsApr 11, 2023
|
|

36 viewsApr 11, 2023
|
|
49 viewsApr 11, 2023
|
|

48 viewsApr 11, 2023
|
|

51 viewsApr 11, 2023
|
|

42 viewsApr 11, 2023
|
|
| 264 files on 22 page(s) |
 |
 |
 |
 |
 |
11 |  |
 |
 |
 |
|
